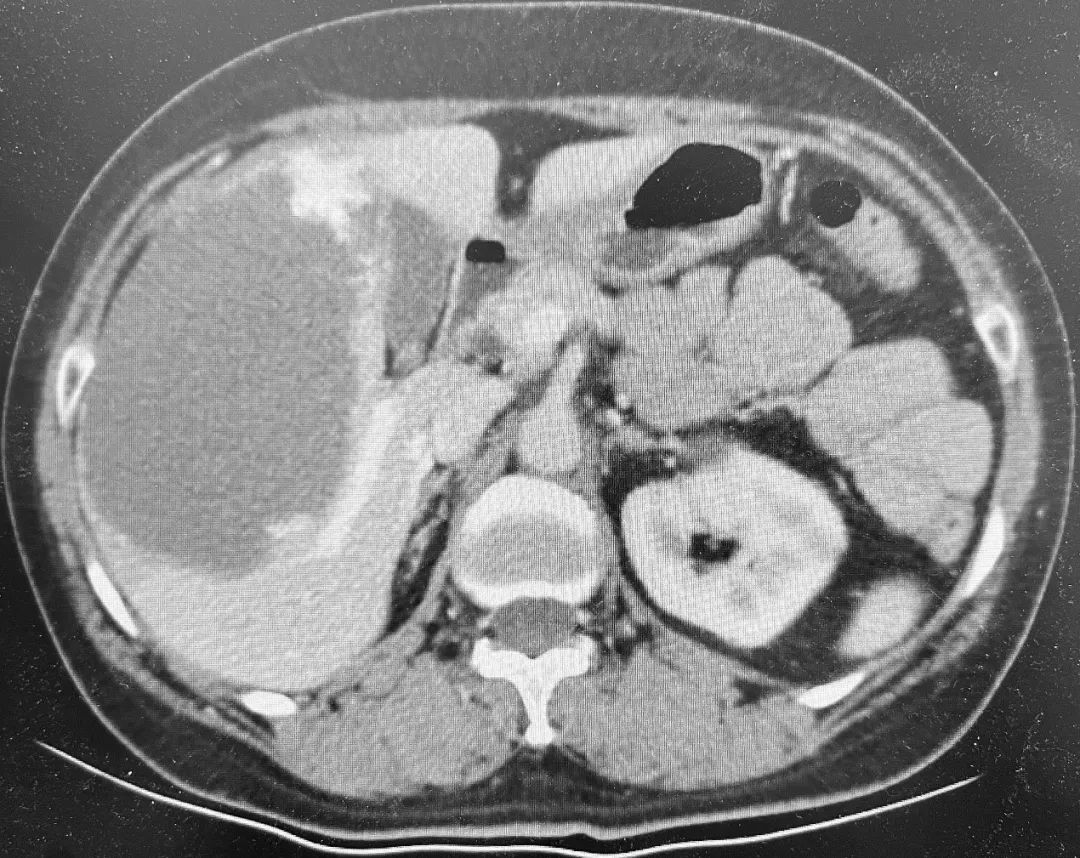

医患一家| 多学科合作治疗合并严重心律失常的巨大肝血管瘤患者
2022-01-21 10:51
来源: 北京号
53岁的王女士平时一直身体很好,这次是来北京看儿子的。临近年关,孩子带着王女士做体检,超声检查偶然发现肝脏长了个13cm的肿物,进一步增强CT确诊为巨大肝血管瘤。

考虑到肝血管瘤的手术并不是非常紧急,普外科将王女士先转至心内科,刘巍主任团队为她成功实施了射频消融治疗,心律失常得到有效控制。

在心脏问题得到处理后,普外科重新将王女士收入院。术前评估发现王女士血管瘤与右肝的肝蒂和肝静脉关系密切,实施右半肝切除是相对容易的手术方式,但右半肝切除会损失20%左右的正常肝组织。在对影像进行详细研判的基础上,结合既往的肝脏手术经验,高鹏骥主任团队选择了难度相对更大但患者获益更多的血管瘤剥除手术。2022年1月6日,在麻醉团队和手术室护理团队的密切配合下,普外科成功为王女士实施了腹腔镜下巨大血管瘤剥除手术,术后在监护室短暂过渡后返回普通病房, 1周后王女士就完全康复出院了。
这例合并严重心律失常巨大肝血管瘤患者的成功诊治,反映出我院各综合科室具备了强大的技术实力和服务能力,能够为北京乃至全国各地患者提供全面优质的医疗服务。
文图丨普外科



打开APP阅读全文
特别声明:本文为北京日报新媒体平台“北京号”作者上传并发布,仅代表作者观点,北京日报仅提供信息发布平台。未经许可,不得转载。


